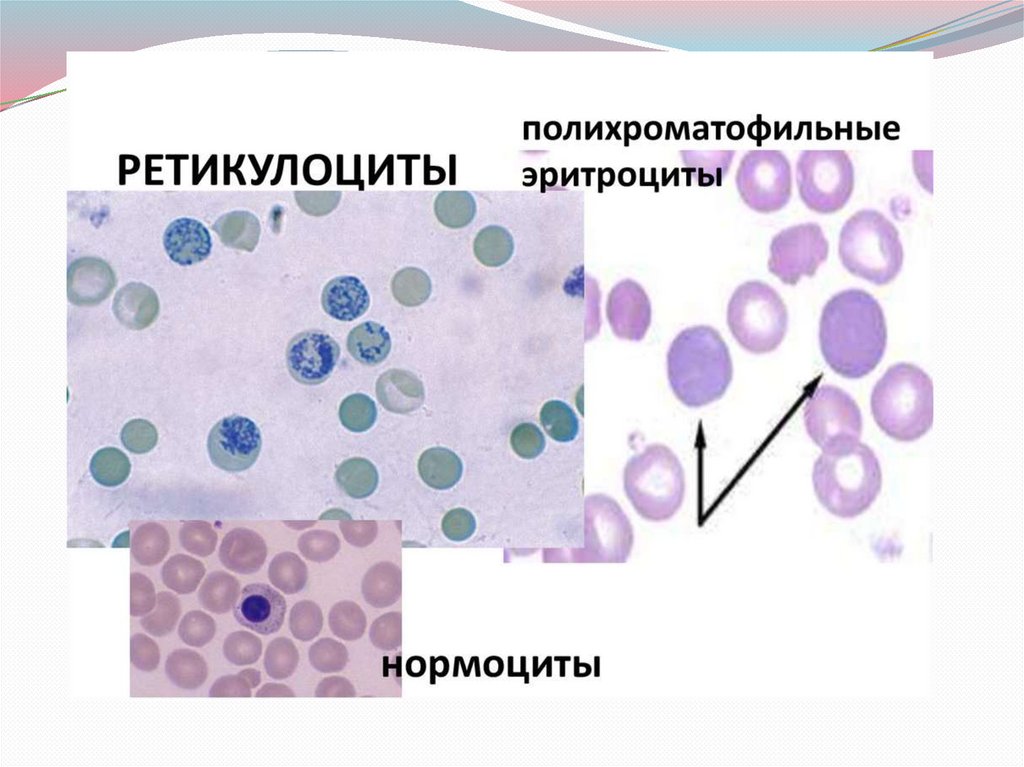
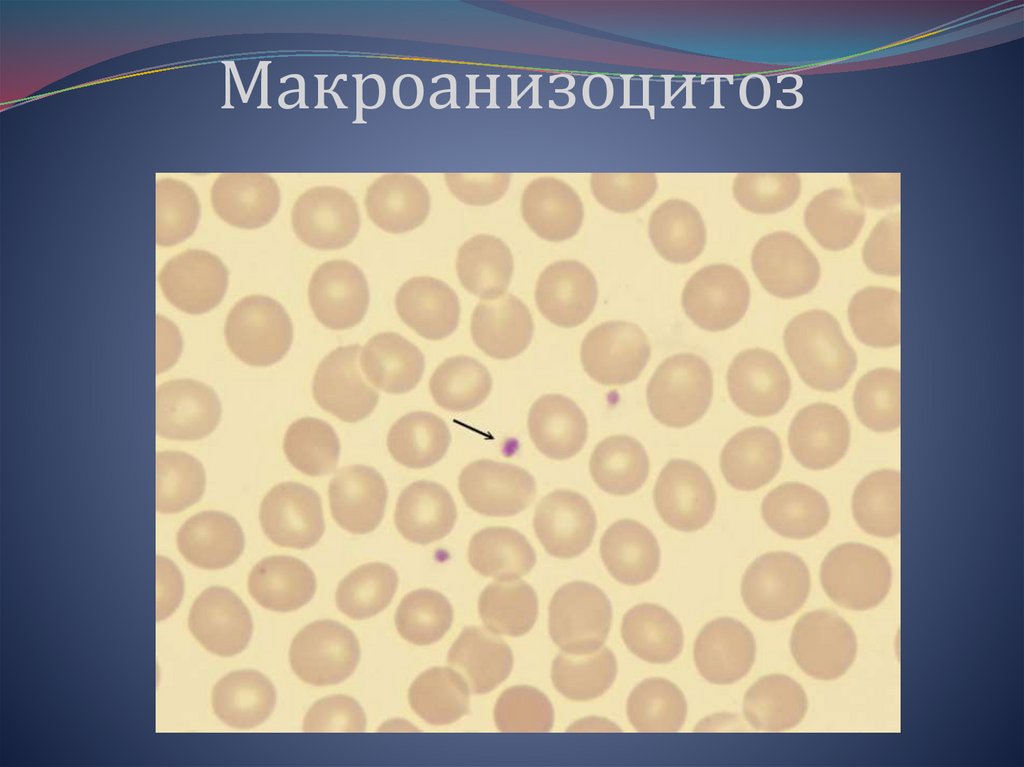
Микроанизоцитоз, гипохромия эритроцитов

Similar presentations:
Изменение показателей гемограммы при патологии эритроцитов
1. БПОУ «Чебоксарский медицинский колледж» Минздрава Чувашии
Изменение показателей гемограммыпри патологии эритроцитов
Подготовила преподаватель
отделения
Лабораторная диагностика:
Никитина А.Н.
Чебоксары 2025
2. Кровеносный сосуд
3. Лейкоцит, окруженный эритроцитами
4.
5.
Различные видынормобластов
6. Различные виды нормобластов
Эритроциты7. Эритроциты
ЭРИТРОПОЭЗЭРИТРОН - система кроветворной ткани от
стволовой клетки до зрелого эритроцита
(эритроцитарный росток).
Эритроцитарный росток
представляет cобой
наиболее
делящуюся
популяцию клеток в
костном мозге.
ВЫВОД: При нормальном эритропоэзе из одного
эритробласта получается 32 эритроцита
8. ЭРИТРОПОЭЗ
9.
Эритробластдиаметр 20 – 25 мкм
высокое
ядерноцитоплазматическое
соотношение
округлая форма ядра
нежно сетчатая структура
хроматина
содержит 1 – 3 нуклеолы
имеет узкий ободок резко
базофильной цитоплазмы
10. Эритробласт
Эритробласты11. Эритробласты
ПронормобластОтличаются от эритробласта:
меньшим
размером (клетка
диаметром 12-18 мкм. )
отсутствием нуклеол в ядре
наличием перинуклеарной зоны
просветления
Структура ядер характеризуются
более
грубым
сплетением
хроматиновых нитей, имеющих
утолщения
и
местами
складывающихся
в
более
компактные и
крупные
комплексы.
В некоторых пронормобластах
еще может местами сохранятся
сравнительно нежное строение.
12. Пронормобласт
13. Пронормобласт
Пронормобласты14. Пронормобласты
Базофильные нормобластыдиаметр 16 – 18 мкм
ядро округлой формы,
насыщено-фиолетового
цвета
расположено центрально
не содержит нуклеол
хроматин
имеет
характерную структуру в
виде « спиц в колесе»
цитоплазма синего цвета
небольшим
ободком
окружает ядро
15. Базофильные нормобласты
Полихроматофильныенормобласты
диаметр 8 – 12 мкм
ядро округлой формы,
темно-фиолетового цвета
расположено центрально
не содержит нуклеол
хроматин с четкой
колесовидной структурой
цитоплазма достаточно
широкая серовато-голубого
цвета
16. Полихроматофильные нормобласты
Оксифильныенормобласты
диаметр 8– 11мкм
ядро темнофиолетового цвета,
пикнотичное
(«вишневая косточка»)
расположено немного
эксцентрично
цитоплазма бледнорозового цвета
17. Оксифильные нормобласты
18.
РетикулоцитыРЕТИКУЛОЦИТ – клетка
диаметром
9-11 мкм. В зависимости от способа
окраски, может быть голубого или
зеленого цвета. Содержит остатки
РНК (нитчато-сетчатую
субстанцию 5 видов) ,
субстанция окрашивается в синий
цвет.
Метод окраски по Алексееву суправитальный.
Особенность окраски
ретикулоцитов заключается в том,
что они воспринимают краску
только в момент, пока клетка,
выведенная из кровеносного русла,
еще жива.
N: 2-10 ‰ или 0,2 – 1%
19. Ретикулоциты
20.
РетикулоцитыВиды ретикулоцитов:
Ядросодержащие
Форма клубка
Форма сетки
Форма неполной сетки
Форма гранулярная
21. Ретикулоциты
22.
23.
24.
25.
26.
ВОПРОСЫ ДЛЯ ПОВТОРЕНИЯ:ПЕРЕЧИСЛИТЕ ВИДЫ НОРМОБЛАСТОВ
ЭРИТРОЦИТАРНОГО РОСТКА:
1.
2.
3.
27. ВОПРОСЫ ДЛЯ ПОВТОРЕНИЯ:
ЧТО ТАКОЕ РЕТИКУЛОЦИТ?КАКУЮ СПЕЦЕФИЦЕСКУЮ
ЗЕРНИСТОСТЬ ОНИ ИМЕЮТ?
28.
29.
ПЕРЕЧИСЛИТЬ ВИДЫ РЕТИКУЛОЦИТОВ:1.
2.
3.
4.
5.
30.
ЭритроцитыЭРИТРОЦИТ- зрелая клетка периферической
крови диаметром 7-8 мкм, розово- красного
цвета. Имеет форму двояковогнутого диска,
более интенсивно окрашенная по
периферии и более светлая в центре.
Установлено, что процесс созревания эритроцитов
происходит под влиянием эритропоэтина, гормона
белковой природы, относящегося к гликопротеидам.
Он вырабатывается преимущественно почками и
способствует превращению клеток –
предшественников эритроцитов ( класс III) в
эритробласты и дальнейшей дифференцировке в
эритроциты.
31. Эритроциты
Эритроциты участвуют вдоставке питательных
веществ(аминокислот,
липидов) к клеткам и тканям,
выполняя питательную
функцию.
Выполняют защитную функцию,
переносят на своей
поверхности антитела.
Принимают участие в процессе
свертывания крови.
32. Эритроциты
Понятие об анемииАнемия или малокровие - патологическое
состояние, характеризующееся уменьшением
общего количества гемоглобина, эритроцитов в
периферической крови и гипоксией органов и
тканей. Нередко анемия является самостоятельным
заболеванием или сопутствующим симптомом
многих внутренних заболеваний, инфекционных и
онкологических болезней.
При анемии наблюдаются общие клинические
признаки: общая слабость, недомогание, головная
боль, головокружение, мелькание «мушек»перед
глазами, шум в ушах, нарушение памяти, снижение
работоспособности.
33. Понятие об анемии
Эти явления возникают вследствиегипоксии
головного мозга (недостаточное снабжение
головного мозга и крови кислородом).
Часто у больных анемией наблюдается бледность
кожи и слизистых оболочек:
-характерная бледно - желтая окраска кожи
свойственна гемолитической анемии;
-сероватый оттенок кожи у больных с ЖДА;
-при острой постгеморрагической анемиимраморный оттенок кожи.
Развитие анемии у больных сопровождается
одышкой и сердцебиением.
34.
Характерной особенностью анемии является:либо абсолютное уменьшение эритроцитарной
массы,
либо функциональная недостаточность системы
эритроцитов в силу пониженного содержания
гемоглобина в каждом отдельном эритроците.
В качестве анемии следует рассматривать те
состояния, при которых наблюдается снижение
концентрации гемоглобина (в граммах на литр крови
-- г/л) для детей от 6 месяцев до 6 лет ниже 110, от 6
до 14 лет -- 120, взрослых женщин -- 120, взрослых
мужчин -- 130.
35.
Морфология эритроцитов при анемияхВ эритроцитах наблюдаются изменения:
- размера
- формы
- окраски
- появляются в крови ядерные формы эритроцитов
(нормобласты)
- различные включения в эритроцитах (тельца Жолли,
кольца Кебота, базофильная пунктация)
Анизоцитоз - появление в крови эритроцитов разных
размеров.
A. Мегалоциты - диаметр больше 11 мкм.
Б. Макроциты - диаметр больше 9 мкм
B. Микроциты - диаметр меньше 6,5 мкм
Г. обломки эритроцитов - шизоциты .
36. Морфология эритроцитов при анемиях
Пойкилоцитоз - появление в крови эритроцитов различнойформы: грушевидные, серповидные, овальные,
шаровидные и др.
Анизохромия - наличие в мазках крови эритроцитов
различной окраски.
Она зависит от количества гемоглобина и объема
эритроцитов.
Нормохромия - нормальная окраска зрелых эритроцитов
Гипохромия - уменьшение интенсивности окраски
эритроцитов (окраска только по ободку)
Гиперхромия - эритроциты интенсивно окрашены, нет
просветления в центре.
Полихроматофилия - эритроциты различных оттенков
фиолетового цвета.
Сиреневый цвет - окрашиваются молодые, незрелые
эритроциты, ретикулоциты.
37.
Анизоцитоз эритроцитов - этопоявление в крови эритроцитов
разных размеров.
38.
Микроанизоцитоз,гипохромия эритроцитов
39. Микроанизоцитоз, гипохромия эритроцитов
Макроанизоцитоз40. Макроанизоцитоз
Микросфероциты(отсутствует центральное просветление в
эритроцитах).
41. Микросфероциты (отсутствует центральное просветление в эритроцитах).
ПойкилоцитыЭритроциты
различной
формы;
каплевидные
грушевидные, с одним или несколькими острыми
шипами (репейниковые эритроциты); с зазубренной
поверхностью (акантоциты); овальные (овалоциты,
эллиптоциты);
серповидные
(менискоциты,
дрепаноциты);
сфероидные
;
мишеневидные,
имеющие одну или две темноокрашенные зоныцентральную и периферическую, между которыми
находится светлоокрашенная зона; планоциты,
имеющие меньшую, чем в норме, толщину.
42. Пойкилоциты
43.
ГипохромныеМенее интенсивно окрашены, чем в норме (при
значительном снижении содержания гемоглобина
окрашивается лишь узкой ободок периферии клетки, в
то же время центральное просветление резко
увеличивается).
44. Гипохромные
ГиперхромныеБолее интенсивно окрашены, чем в норме.
Анизохромная может быть выявлено в одном и том же
препарате в различных эритроцитах, а также в одном и
том же эритроците.
45. Гиперхромные
ПолихроматофильныеЭритроциты окрашены в оттенок сиреневого цвета.
46. Полихроматофильные
В периферической крови могут появляться:1.Ядерные формы эритроцитов нормобласты (базофильные,
полихроматофильные, оксифильные) и даже
пронормобласты, эритробласты.
2.Эритроциты с включениями:
а) тельца Жолли (остатки ядра) - фиолетово красные включения
б) кольца Кебота (остатки ядерной оболочки) бледно-розовые включения в виде элипсов или
восьмерок.
в) базофильная пунктация – мелкая фиолетовая
зернистость
47.
Остатки ядерных образований в эритроцитахОсвобождение клетки от ядра.
Т.Жолли – это остатки ядерного хроматина,
имеющие округлую форму, достигая
размера до 1 мкм и более, окрашены в
красно-фиолетовый цвет.
К.Кебота – это остатки ядерной мембраны
или
митотических нитей, имеют вид полных
или неполных колец, восьмеркообразных
фигур.
Часто встречаются при
мегалобластической анемии.
Базофильная зернистость – рассеяные
гранулы синего цвета. Появляются при
интоксикации свинцом, алкоголем, при
талассемии.
48. Остатки ядерных образований в эритроцитах
Классификация анемийНаиболее распространенной является патогенетическая
классификация.
I. По причине возникновения – 3 группы:
1. Постгеморрагические – вследствие кровопотерь:
а) острая постгеморрагическая
б) хроническая постгеморрагическая
2. Анемии, обусловленные нарушением кровообразования:
а) В12 (фолиево – дефицитная)
(болезнь Аддисона - Бирмера, пернициозная анемия)
б) железодефицитные
в) гипо и апластические
3.Анемии, вследствие усиленного кроворазрушения - гемолитические:
Врожденные и приобретенные:
а) анемии, обусловленные внутрисосудистым гемолизом
- острые и хронические
б) анемии, обусловленные внутриклеточным гемолизом
49. Классификация анемий
Описание морфологии эритроцитов вбланке общего анализа крови:
Анизоцитоз, пойкилоцитоз, если эритроциты
изменены все 100%, отмечаем анизоцитоз «4»,
пойкилоцитоз «4».
Если 75% - «3», 50% - «2», 25% - «1»
Полихроматофилия - единичные
полихроматофилы в поле зрения – «1», если до 10
в noле зрения – «2», если больше 10 – «3».
Нормобласты. При подсчете лейкоцитарной
формулы отмечают на одной из клавиш счетчика
(1,2,3)- например, подсчитали 100 лейкоцитов и 2
нормобласта (всего 102 клетки). В бланке анализа
отмечаем: нормобласты - 2 на 100 лейкоцитов.
50.
II. По лабораторным показателям.По цветовому показателю:
а) нормохромные (цветовой пок. 0,86-1,1)
б) гипохромные (цветовой пок. < 0,8)
в) гиперхромные (цветовой пок. > 1,1)
По диаметру эритроцитов:
а) нормоцитарные (д. - 7-8 мкм)
б) микроцитарные (д. < 7 мкм)
в) макроцитарные (д. > 8 мкм)
г) мегалоцитарные (д. > 11 мкм)
51.
I. Анемии вследствие кровопотерьили постгеморрагические
Острая форма возникает при быстрой потере большого
количества крови, которая может быть вызвана разрывом
крупных сосудов при травмах, маточных, легочных,
почечных, желудочных кровотечениях.
Картины крови:
в первые часы
эритроциты и гемоглобин в норме
гипоксия
через 1-2 дня
количество эритроцитов и гемоглобина в единице объема
снижается
ЦПК в норме - нормохромная анемия
52. I. Анемии вследствие кровопотерь или постгеморрагические
на 4-5 деньмного ретикулоцитов
гемоглобин повышается
гипохромия
анизоцитоз (макроцитоз)
встречаются полихроматофилы
лейкоцитоз до 12-20-109 в 1л
сдвиг лейкоцитарной формулы до метамиелоцитов
тромбоцитоз
СОЭ повышено
Хроническая форма развивается в результате небольших,
но часто повторяющихся кровопотерь (при геморрое, язве
желудка и 12-перстной кишки, операциях ЖКТ, носовых
кровотечениях) переходящих в железодефицитную
анемию.
53.
ЧТО ОЗНАЧАЕТ ТЕРМИНАНИЗОЦИТОЗ?
54.
Как называется появление вкрови эритроцитов
различной формы?
55.
РАСШИФРОВАТЬ ПОКАЗАТЕЛИГЕМОГРАММЫ:
WBC RBC HGB -
56. РАСШИФРОВАТЬ ПОКАЗАТЕЛИ ГЕМОГРАММЫ:
WBC (white blood cells)-лейкоциты(Количество лейкоцитов крови
(х109/л).)
RBC (red blood cells) – эритроциты
(Количество эритроцитов крови
(х1012/л).)
HGB (hemoglobin) – гемоглобин
(Концентрация гемоглобина (г/л))
57.
II. Железодефицитные анемииЖелезодефицитные анемии возникают вследствие
нарушения кровообразования.
Причинами возникновения железодефицитной анемии
могут быть:
недостаточное поступление железа в организм при
нарушении питания (голодание, молочно-растительная
диета)
повышенные
потери
железа
при
хронических
постгеморрагических анемиях
повышение потребления железа в периоды роста,
беременности и лактации
недостаточное усвоение железа при хронических
энтеритах, резекции части тонкого кишечника и желудка
58. II. Железодефицитные анемии
у детей потеря железа из-за экссудативно-катаральногодиатеза (слущивание эпителиальных клеток за счет
снижения железа)
снижение железа доноров, особенно у женщин
кровопотеря у взрослых: маточные кровотечения,
патологические менструации, кровотечения ЖКТ - могут
иметь скрытый характер - эти кровотечения трудно
диагностировать (гастроэнтериты, язвенные болезни
двенадцатиперстной кишки и желудка, варикозное
расширение вен пищевода и прямой кишки)
паразитарные гемогельминтозы (анкилостомы, власоглав)
Богаты железом - печень свиная, говяжья, говядина,
толокно, желток . Умеренное содержание железа гранат, яблоко, горох, гречневая крупа, соевый белок.(
овсянка заменяет железо без мяса).
59.
Общеанемические признакибледность кожи и видимых слизистых оболочек
общая слабость
снижение работоспособности
сердцебиение, одышка
головная боль, головокружение
шум в ушах
60. Общеанемические признаки
Симптомы, характерные только для железодефицитноианемии
кожа бледная, с легким зеленоватым оттенком, легко
наступает румянец, она сухая, дряблая, шелушится,
легко образуются трещины
волосы теряют блеск, истончается, легко ломаются,
редеют, рано седеют
ногти тонкие, матовые, легко расслаиваются и ломаются
средний и указательный пальцы имеют ложкообразную
форму при многолетней железодефицитной анемии
отмечается мышечная слабость
поражение слизистой оболочки (трещины на кончике и
по краям языка, на губах)
зубная эмаль с прожилками
61.
снижение аппетита, потребность в кислой, соленой,острой пище
характерно затруднение при глотании сухой и твердой
пищи (чувстве першения и инородных тел в глотке)
может быть лихорадка (температура не более 37°С)
Картины крови:
резкое снижение уровня гемоглобина
ЦПК снижен (до 0,5-0,6)
гипохромия эритроцитов (эритроциты колесовидные, с
большим просветлением в центре)
анизоцитоз (микроцитоз)
пойкилоцитоз
в тяжелых случаях появляются нормобласты
СОЭ незначительно увеличена
ретикулоциты в норме или иногда повышенно
лейкоциты в пределах нормы
62.
Клинические проявления анемииЯрко-красный
язык
и
заеды в углах рта при
анемии
(ангулярный
стоматит).
Сероватая бледность кожи
лица при тяжелой степени
анемии.
Сравнение
цвета
кожи
здорового
человека
и
пациента с пернициозной
анемией.
В редки
63. Клинические проявления анемии
Ногти вогнутые, легко ломаются, уплощены, бледнойокраски, ложкообразные, имеют бороздки
64. Клинические проявления анемии
Желтушное прокрашиваниекожи и склер при
гемолитической анемии
различной этиологии
Кровоизлияния в сетчатку
65. Клинические проявления анемии
Микроцитарныегипохромныеанемии
MCV – менее 80 фл
MCH – менее 27 пг
MCHC – менее 32 г/дл
RDW – в норме
или увеличен
ЖДА, талассемия,
сидеробластная
анемия,
отравление
свинцом, анемия
хр.заболеваний
Снижение Hb
СВС/MCV
Нормоцитарныенормохромные
анемии
MCV – 80-100 фл
MCH – в пределах нормы
MCHC – в пределах нормы
RDW – обычно в пределах
нормы
Анемии при ХПН
Постгеморрагические
Апластические.
Миелофтиз. Анемия
хр.заболеваний.
Эндокринопатии
Макроцитарныенормо – или
гиперхромные
анемии
MCV – более 100 фл
MCH – менее 32 пг
MCHC – в пределах нормы
RDW – в норме или увеличен
Мегалобластная: В 12,
фолиево дефицитные
Миелодисплазия, анемия
лекарственного генеза.
Немегалобластная:
ретикулоцитоз,
болезни печени, гипотиреоз,
АИГА
66.
67.
68.
69.
III. B12 (фолиево)дефицитные анемииB12 (фолиево) - дефицитные анемии относятся к
заболеваниям, возникающим вследствие нарушения
образования крови.
В12-дефицитные анемии возникают при недостатке
цианкобаламина (витамина Bi2). Цианкобаламин участвует
в строении нервной ткани, отвечает за память, внимание,
участвует в синтезе белков, аминокислот, в нормальном
пищеварении. Частично В12 синтезируется микрофлорой
кишечника, а остальная часть поступает с пищей, поэтому
дефицит В)2 возникает в пожилом возрасте в течение 10-12
лет. В12 необходим детям, беременным, новорожденным,
т.к. идет закладка нервной ткани.
70. III. B12 (фолиево)-дефицитные анемии
Причины дефицита В12:недостаточное
употребление в пищу мяса,
молочных
продуктов,
печени,
т.е
недостаточное поступление и всасывание в
пищеварительном тракте
(В 12 откладывается в печени
и по мере
необходимости поступает в костный мозг для
обеспечения нормального кроветворения)
нарушение всасывания, связанные в первую
очередь с отсутствием гастрогликопротеида,
который вырабатывается клетками желудка и это
связано с атрофическими изменениями слизистой
оболочки желудка.
71.
не усваивание витамина B12 при гаптеновойболезни - это наследственная врожденная
патология, связанная с неусвоением белков,
связывающих витамин B12.
конкурентное
заболевание,
связанное
с
паразитическим поглощением широким лентецом,
он поглощает витамин B12 в очень больших
количествах для его роста и развития.
различные нарушения в пищеварительном тракте
72.
Картина крови:количество эритроцитов резко снижено (в норме
25-30 в поле зрения, при анемии - 10-12 в поле
зрения) (иногда менее 1•10 ^12 )
Нв резко снижен (до 20г/л)
ЦПК выше 1, в тяжелых случаях 1,4-1,8
мегалоциты до 30% (-12-14 мкм)
макроцитоз до 60%
гиперхромия
анизоцитоз
резкий пойкилоцитоз (встречаются обломки
эритроцитов - шизоциты)
73.
эритроциты с базофилъной пунктацией, с остатками ядра ввиде телец Жолли и колец Кебота
нормоциты (оксифильные мегалобласты могут содержать
сразу кольца Кебота, тельца Жолли, базофильную
пунктацию эритроцитов)
количество ретикулоцитов снижено
развивается лейкопения с нейтропенией относительный
лимфоцитоз
анэозинофилия
гиперсегментация (до 8-10 сегм.) ядер нейтрофилов
палочкоядерные нейтрофилы отсутствуют
сдвиг лейкоформулы вправо
тромбоциты снижены
74.
Фолиево-дефицитные анемии.Фолиевая кислота питает мозг и участвует для
формирования нервной системы. Кислота не синтезируется
кишечной микрофлорой, поступает с пищей (наиболее
богаты печень и листья шпината, содержится в коровьем и
женском молоке).
Соли фолиевой кислоты откладываются в печени и
поступают в костный мозг для осуществления
нормального кроветворения.
Причины:
1. Фолиево-дефицитная анемия может развиваться при
изолированном
дефиците
фолиевой
кислоты
и
новорожденных или недоношенных детей.
2.
Длительно
принимающих
противосудорожные
препараты.
3. У лиц, страдающих алкоголизмом.
75.
Нормальный эритропоэз со всемиэлементами красного ростка
76. Нормальный эритропоэз со всеми элементами красного ростка
Диагностика анемий начинается со сбора анамнеза,уделяется особое внимание характеру питания, приему
лекарственных средств, воздействию вредных
производственных факторов, наличию очагов
хронической инфекции, операции на желудочнокишечном тракте и т. д.
Проводится внешний осмотр больного, оценивается
состояние кожи и слизистых, волос и ногтей.
77.
Степени тяжести:1. Легкая (гемоглобин 90--110 г/л),
2. Средняя (гемоглобин 70--90 г/л)
3. Тяжелая (гемоглобин ниже 70 г/л).
78. Степени тяжести:
Обязательными являются: общий анализ крови(определение количества эритроцитов, концентрации
гемоглобина,
ретикулоцитов,
тромбоцитов,
лейкоцитов, СОЭ, лейкоформулы, определение
времени свертывания крови и длительности
кровотечения. Для уточнения диагноза проводятся
лабораторные
исследования
гематокрита,
осмотической
стойкости
эритроцитов,
сывороточного железа, общей железосвязывающей
способности и т. д.

medicine
medicine








